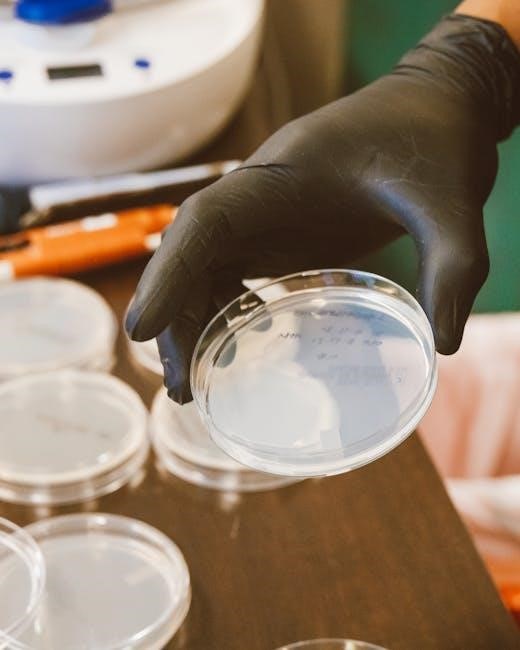

Understanding the Asthma Control Test (ACT) for Ages 4-11
Finding a reliable ACT 4-11 PDF requires accessing official sources like the Asthma and Allergy Foundation of America (AAFA) or the National Heart, Lung, and Blood Institute (NHLBI).
What is the ACT for Children?
The Asthma Control Test (ACT) for children aged 4-11 is a simple questionnaire designed to assess how well a child’s asthma is controlled. It’s a valuable tool for parents and healthcare providers to understand the frequency and severity of asthma symptoms experienced by the child. Accessing a reliable ACT 4-11 PDF is the first step in utilizing this assessment.
This questionnaire isn’t a diagnostic tool; rather, it provides a snapshot of current asthma control. The ACT helps determine if asthma is well-controlled, partially controlled, or uncontrolled, guiding treatment decisions. Official sources, such as the Asthma and Allergy Foundation of America (AAFA) and the National Heart, Lung, and Blood Institute (NHLBI), offer downloadable ACT 4-11 PDF versions for convenient use. Consistent use of the ACT 4-11 PDF aids in tracking progress and communicating effectively with doctors.
Why is Asthma Control Important?
Effective asthma control significantly improves a child’s quality of life, allowing them to participate fully in daily activities like school, sports, and play. Poorly controlled asthma can lead to frequent symptoms, emergency room visits, and hospitalizations. Utilizing an ACT 4-11 PDF regularly helps monitor and manage these risks.
Consistent assessment with the ACT 4-11 PDF empowers parents to proactively address potential issues before they escalate. It facilitates open communication with healthcare providers, enabling informed decisions about medication and treatment plans. Accessing a current ACT 4-11 PDF from trusted sources like the AAFA or NHLBI ensures accurate assessment. Ultimately, good asthma control minimizes disruptions and maximizes a child’s well-being, and the ACT 4-11 PDF is a key component of this process.

The ACT Questionnaire: A Detailed Look
The ACT 4-11 PDF contains questions designed to assess asthma control over the past four weeks, providing valuable insights for management.
ACT Questions for Children Aged 4-11
The ACT for children aged 4-11, available as a PDF, typically includes questions tailored to their understanding and experiences with asthma. These questions, often answered with the help of a parent or caregiver, assess how well asthma symptoms are controlled. Expect inquiries about daytime symptoms – how often coughing, wheezing, or shortness of breath interfere with daily activities like playing or attending school.
Nighttime symptoms are also evaluated; specifically, how often asthma wakes the child up at night. The questionnaire probes limitations on activity levels due to asthma, and the frequency of needing to use rescue medication like an inhaler. A key aspect involves understanding how much the asthma impacts the child’s normal routines. The PDF format ensures standardized administration and consistent data collection for effective asthma management.
Scoring the ACT: Interpreting Results
The ACT 4-11 PDF provides a straightforward scoring system, typically totaling points from each answered question. A total score indicates the level of asthma control. Scores generally range from 0 to 27, with higher scores representing better control. A score of 25 or higher suggests well-controlled asthma, indicating minimal symptom interference. Scores between 20 and 24 suggest partially controlled asthma, requiring potential adjustments to the treatment plan.
Lower scores, below 20, signify uncontrolled asthma, signaling a need for immediate review with a healthcare provider. The PDF often includes a clear interpretation guide, categorizing scores into control levels. It’s crucial to remember the ACT is a snapshot in time and should be used alongside clinical assessment for comprehensive asthma management.
Factors Influencing Asthma Control in Children
The ACT 4-11 PDF doesn’t directly address influencing factors, but understanding triggers and medication adherence is vital for accurate assessment results.
Environmental Triggers and Asthma

While the ACT 4-11 PDF itself doesn’t detail environmental triggers, recognizing them is crucial for accurate test results and overall asthma management. Common triggers include allergens like pollen, dust mites, and pet dander, as well as irritants such as smoke, air pollution, and strong odors.
Exposure to these elements can worsen asthma symptoms, potentially leading to a lower ACT score. Parents and caregivers should proactively minimize a child’s exposure to known triggers. Regularly cleaning the home, using air purifiers, and avoiding outdoor activities during high pollen counts can be beneficial.
Understanding a child’s specific triggers, and documenting their impact, can help healthcare providers tailor an effective asthma action plan, ultimately improving ACT scores and quality of life.
Medication Adherence and its Impact
The ACT 4-11 PDF assesses asthma control, heavily influenced by consistent medication adherence. Regularly using prescribed controller medications, even when a child feels well, is vital for preventing symptom flare-ups and maintaining a high ACT score.
Inconsistent medication use directly correlates with poorer asthma control and lower test results. Establishing a routine for medication administration, utilizing reminders, and open communication between caregivers, children, and healthcare providers are essential.
Proper inhaler technique is also crucial; ensure correct usage to maximize medication effectiveness. Documenting any difficulties with adherence during ACT assessments helps doctors adjust treatment plans for optimal outcomes.

Using the ACT to Manage Asthma
Regularly utilizing the ACT 4-11 PDF allows for tracking asthma control over time, providing valuable insights for healthcare providers to refine treatment strategies.
Regular ACT Assessments: Tracking Progress
Consistent use of the Asthma Control Test (ACT) for children aged 4-11, readily available as a downloadable PDF from reputable sources, is crucial for effectively monitoring asthma management. Regularly completing the ACT questionnaire – ideally every 4 weeks, or as directed by a healthcare professional – establishes a baseline and reveals trends in symptom control.
By documenting ACT scores over time, parents and caregivers can identify periods of well-controlled asthma versus those requiring intervention. This longitudinal data is invaluable when communicating with doctors, allowing for informed decisions regarding medication adjustments or lifestyle modifications. The ACT 4-11 PDF provides a standardized, simple method for objective assessment, moving beyond subjective perceptions of asthma severity. Tracking progress empowers families to actively participate in their child’s asthma care.
Communicating ACT Results with Healthcare Providers
Sharing completed Asthma Control Test (ACT) 4-11 PDF results with your child’s doctor is a vital step in optimizing their asthma management plan. Don’t hesitate to bring the completed form to appointments, or transmit it electronically if your provider offers that option.
ACT scores provide objective data, supplementing your observations about your child’s symptoms. This allows for a more informed discussion about the effectiveness of current medications and identifies areas needing adjustment. Be prepared to discuss any trends observed in the ACT scores over time. A clear presentation of the ACT results, easily obtained from the downloadable PDF, facilitates collaborative decision-making and ensures your child receives the most appropriate care.

Accessing the ACT 4-11 PDF
Locate the ACT 4-11 PDF through official organizations such as the Asthma and Allergy Foundation of America (AAFA) and NHLBI websites.
Official Sources for the ACT PDF
When seeking the Asthma Control Test (ACT) for children aged 4-11 in PDF format, prioritizing official sources is crucial for accuracy and reliability. The Asthma and Allergy Foundation of America (AAFA) is a primary resource, often providing downloadable versions of the questionnaire and related materials on their website.
Similarly, the National Heart, Lung, and Blood Institute (NHLBI), a part of the National Institutes of Health, frequently offers asthma management tools, including the ACT, available for download. These organizations ensure the PDF is the most current version, reflecting any updates or revisions to the test.
Avoid downloading the ACT from unofficial websites, as these may contain outdated or inaccurate information. Always verify the source and look for the official logos of AAFA or NHLBI to guarantee the authenticity of the document.
Downloading and Printing the ACT Form
Once you’ve located the ACT 4-11 PDF on a trusted source like the AAFA or NHLBI website, the download process is typically straightforward. Look for a clear “Download PDF” or similar button, and save the file to your computer or device. Ensure your PDF reader is up-to-date for optimal viewing and printing.
To print the form, open the downloaded PDF and select the “Print” option. Adjust the print settings as needed – standard paper size and orientation are generally recommended. Consider printing a copy for your healthcare provider and keeping one for your records.
Before printing, preview the document to confirm all questions are legible and the layout is correct. A clear, well-printed form ensures accurate completion and interpretation of the results.

Troubleshooting Common Issues
If the ACT 4-11 PDF is unclear, revisit official sources for a fresh download. Lost results require re-taking the test for accurate tracking.
Difficulty Understanding the Questions
When encountering challenges with the ACT 4-11 PDF questionnaire, remember that clarity is key for accurate results. Parents or caregivers should carefully read each question aloud to the child, ensuring they fully grasp the meaning before responding.
Break down complex phrasing into simpler terms, tailoring the language to the child’s age and comprehension level. Visual aids, like demonstrating what “coughing” or “wheezing” sounds like, can be incredibly helpful. If a question still proves confusing, consult the official ACT resources or discuss it with the child’s healthcare provider.
Don’t hesitate to rephrase the question in different ways to ensure understanding. The goal is for the child to answer honestly based on their recent asthma experiences, not on how they think they should answer.
Lost or Forgotten ACT Results
If you’ve completed the ACT 4-11 PDF and misplaced the results, recreating the assessment is the most reliable course of action. Retake the questionnaire as accurately as possible, recalling the child’s asthma control over the past four weeks.
Regularly documenting ACT scores alongside asthma action plan updates is crucial. Consider creating a dedicated file – physical or digital – to store completed ACT forms and related medical information.
During healthcare appointments, proactively share the most recent ACT results with the doctor. If you consistently struggle to retain records, explore digital solutions like secure health apps or patient portals offered by your provider.

The Connection Between ACT Scores and Asthma Action Plans
ACT 4-11 PDF results directly inform adjustments to a child’s asthma action plan, guiding healthcare providers in tailoring treatment for optimal control.
How ACT Results Inform Action Plan Adjustments
Utilizing the ACT 4-11 PDF results empowers healthcare providers to make informed decisions regarding asthma action plan modifications. A consistently low ACT score signals inadequate asthma control, potentially necessitating an increase in preventative medication dosage or the addition of a new controller medication. Conversely, consistently high scores may suggest a possibility of safely stepping down medication, always under a doctor’s supervision.
The ACT helps pinpoint specific asthma symptoms impacting a child’s daily life, allowing for targeted adjustments. For example, frequent nighttime awakenings indicated by the ACT might prompt a review of nighttime controller medication. Furthermore, the ACT provides a baseline for tracking the effectiveness of any changes made to the action plan, ensuring ongoing asthma management success. Regular monitoring with the ACT 4-11 PDF is crucial for personalized care.
Working with Your Doctor to Update Your Plan
Sharing your child’s completed ACT 4-11 PDF results with their doctor is a vital step in optimizing their asthma management. Don’t attempt to adjust medications independently; always collaborate with a healthcare professional. Bring the completed form to appointments and openly discuss any trends or concerns observed during regular assessments.
Your doctor will interpret the ACT scores alongside a comprehensive evaluation of your child’s asthma history, symptoms, and triggers. This collaborative approach ensures the action plan remains tailored to their individual needs. Be prepared to discuss any difficulties completing the ACT or understanding the questions. A well-adjusted plan, informed by the ACT 4-11 PDF, promotes better asthma control and improved quality of life.

Beyond the ACT: Additional Asthma Management Tools
While the ACT 4-11 PDF offers valuable insights, consider supplementing it with peak flow meter monitoring and detailed asthma diary keeping for comprehensive tracking.
Peak Flow Meter Monitoring
Complementing the Asthma Control Test (ACT) 4-11 PDF with peak flow meter monitoring provides a more objective measure of lung function. This simple device measures how quickly your child can exhale, indicating airway narrowing even before symptoms appear. Regular peak flow readings, recorded alongside ACT scores, offer a comprehensive view of asthma control.
Establishing a “personal best” peak flow is crucial. Your healthcare provider will help determine this based on your child’s age, height, and overall health. Daily monitoring, and especially during illness, allows for early detection of worsening asthma. Comparing current readings to the personal best, and the zones (green, yellow, red) defined by your doctor, guides appropriate medication adjustments. Consistent peak flow data, shared with your doctor alongside the completed ACT 4-11 PDF, empowers informed treatment decisions.
Asthma Diary Keeping
Alongside utilizing the Asthma Control Test (ACT) 4-11 PDF, maintaining a detailed asthma diary offers valuable insights into your child’s condition. This diary should record daily symptoms – coughing, wheezing, shortness of breath – their severity, and any potential triggers encountered, like allergens or exercise.
Documenting medication usage, including dosages and times, is essential. Note peak flow meter readings alongside ACT scores and symptom details for a holistic picture. The diary should also capture environmental factors, such as pollen counts or air quality. Regularly reviewing this information with your healthcare provider, alongside the completed ACT 4-11 PDF, helps identify patterns and refine the asthma action plan. A well-maintained asthma diary empowers proactive management and improved control.

Resources for Parents and Caregivers
The Asthma and Allergy Foundation of America (AAFA) and the National Heart, Lung, and Blood Institute (NHLBI) offer valuable ACT 4-11 PDF resources;
Asthma and Allergy Foundation of America (AAFA)
The Asthma and Allergy Foundation of America (AAFA) is a leading non-profit organization dedicated to saving lives and improving the quality of life for people affected by asthma and allergies. They provide a wealth of information and resources, including details about the Asthma Control Test (ACT) for children aged 4-11.
AAFA’s website often features downloadable versions of the ACT questionnaire in PDF format, making it easily accessible for parents and caregivers. You can find guidance on how to properly administer the test, understand the scoring, and interpret the results. They emphasize the importance of regular ACT assessments to track a child’s asthma control over time.
Furthermore, AAFA offers educational materials explaining how ACT results can inform discussions with healthcare providers and contribute to personalized asthma action plans. Their resources are designed to empower families to actively participate in managing their child’s asthma effectively, leading to improved health outcomes and a better quality of life.
National Heart, Lung, and Blood Institute (NHLBI)
The National Heart, Lung, and Blood Institute (NHLBI), part of the National Institutes of Health, conducts and supports research to prevent and treat heart, lung, blood, and sleep disorders, including asthma. NHLBI provides evidence-based guidelines and resources for asthma management, often referencing the Asthma Control Test (ACT).
While NHLBI may not directly host a downloadable ACT 4-11 PDF, their website offers comprehensive information about asthma control assessment tools and their role in effective treatment. They detail the importance of regularly monitoring asthma symptoms and using validated questionnaires like the ACT to gauge control levels.
NHLBI’s resources emphasize collaboration between patients, families, and healthcare professionals to develop individualized asthma action plans based on ACT results and other clinical findings. They promote a proactive approach to asthma management, empowering individuals to take control of their health and minimize asthma-related complications.